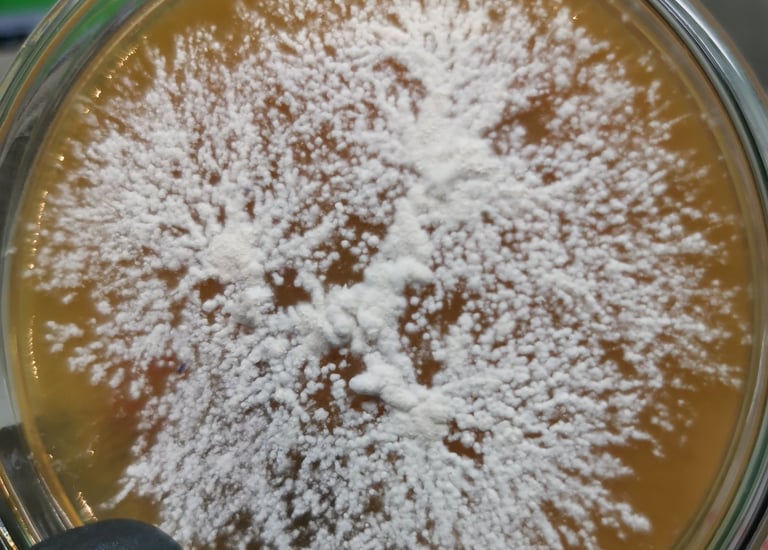
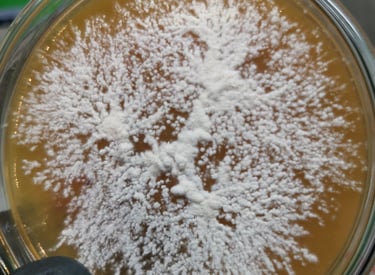

O mnie
Ekspert w dziedzinie farmacji i fitoterapii z 20-letnim doświadczeniem w badaniach nad grzybami i ich biotechnologią.


Zainteresowania

Biotechnologia grzybów
Szczególnie interesują mnie tematy związane z biosyntezą i pozyskiwaniem biologicznie aktywnych metabolitów wtórnych z grzybów. Od kilku lat rozwijam projekt specjalistycznego bioreaktora FUNGOTRON, dzięki któremu możliwa jest efektywna biosynteza m.in. erinacyny A i kwasów ganoderowych. http://fungo.tech


Ekstrakcja i oczyszczanie związków naturalnych
Jestem autorem metod oczyszczania kilkunastu związków lub frakcji czynnych z roślin i grzybów, m.in. erinacyn, hericenów, hericenonów, mykosteroli, antocyjanów, procyjanidyn, kannabinoidów, polisacharydów i wielu innych.




Chromatografia TLC i HPLC
Opracowałem kilkadziesiąt metod analizy jakościowej i ilościowej związków naturalnych z zastosowaniem chromatografii cienkowarstwowej i wysokosprawnej chromatografii cieczowej.
Nanotechnologia
Moje projekty nanotechnologiczne obejmują nowe metody wytwarzania nanocząstek selenu, srebra oraz fullerenów i pochodnych grafenu do zastosowań medycznych i w przemyśle kosmicznym.